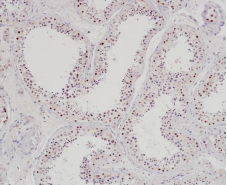

EZHIP Rabbit Monoclonal Antibody(ARB952)
CAT.NO. : ARB6744
RMB Please choose
RMB Please choose
Size:
Trail, Bulk size or Custom requests Please contact us
*产品价格可能会有所调整,请以品牌方官网实时更新的价格为准,以确保准确性。
Background
EZHIP inhibits PRC2/EED-EZH1 and PRC2/EED-EZH2 complex function by inhibiting EZH1/EZH2 methyltransferase activity, thereby causing down-regulation of histone H3 trimethylation on Lys-27 (H3K27me3). EZHIP limits the enzymatic activity of PRC2 and lessens the interaction between the core complex and its accessory subunits, but does not interfere with PRC2 recruitment to chromatin. Deletion of Ezhip in mice leads to a global increase in H3K27me2/3 deposition both during spermatogenesis and at late stages of oocyte maturation. This does not affect the initial number of follicles but associated with a reduction of follicles in aging.
EZHIP is usually expressed in normal testis tissue and multitumor tissues.
EZHIP is a negative regulator of histone H3 methylation.
EZHIP is usually expressed in normal testis tissue and multitumor tissues.
EZHIP is a negative regulator of histone H3 methylation.
Application
|
Application |
Dilution Ratio |
|
IHC |
1:100 - 1:200 |
Overview
|
Predicted Molecular Wt |
51kDa |
|
Species Cross-reactivity |
Human |
|
Applications |
IHC-P |
|
Purity |
ProA affinity purified IgG |
|
Form |
Liquid |
|
Swissprot ID |
Q86X51 |
|
Subcellular location |
Nucleus |
|
Recommended Method |
Heat induced epitope retrieval with Tris-EDTA buffer (pH 9.0), primary antibody incubate at RT (18℃-25℃) for 30 minutes |
|
Storage Buffer |
PBS 59%, Sodium azide 0.01%, Glycerol 40%, BSA 0.05% |
Data
Immunohistochemistry (Formalin/PFA-fixed paraffin-embedded sections) analysis of human testis labelling EZHIP with EZHIP Rabbit Monoclonal Antibody(ARB952)
Storage
Store at -20°C. Stable for one year from the date of shipment.
Research Use Only
For Research Use Only. Not for use in diagnostic procedures.
New Products
